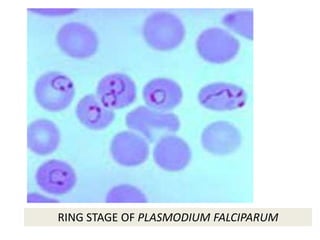
RING STAGE OF PLASMODIUM FALCIPARUM

1) Malaria is caused by protozoan parasites of the genus Plasmodium transmitted via mosquito bites. It is prevalent in tropical and subtropical regions where mosquitoes can breed.
2) Bovine Spongiform Encephalopathy (BSE), also known as mad cow disease, is a fatal brain disease caused by prions. Cattle can contract BSE from eating rendered protein in feed that contains infected tissue.
3) Prion diseases like BSE and its human form Variant Creutzfeldt-Jakob Disease (vCJD) are transmitted when humans consume meat infected with prions, which are very resistant to heat sterilization and other methods.